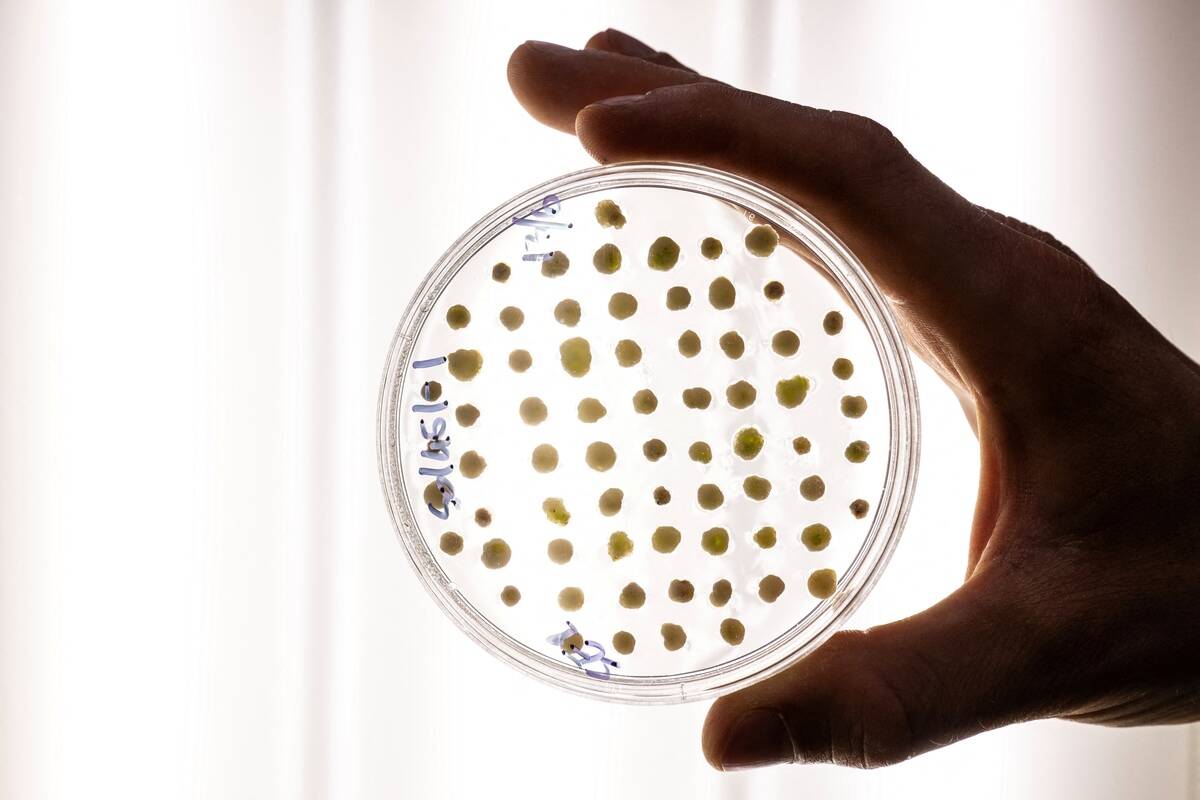
GettyImages-2224774844
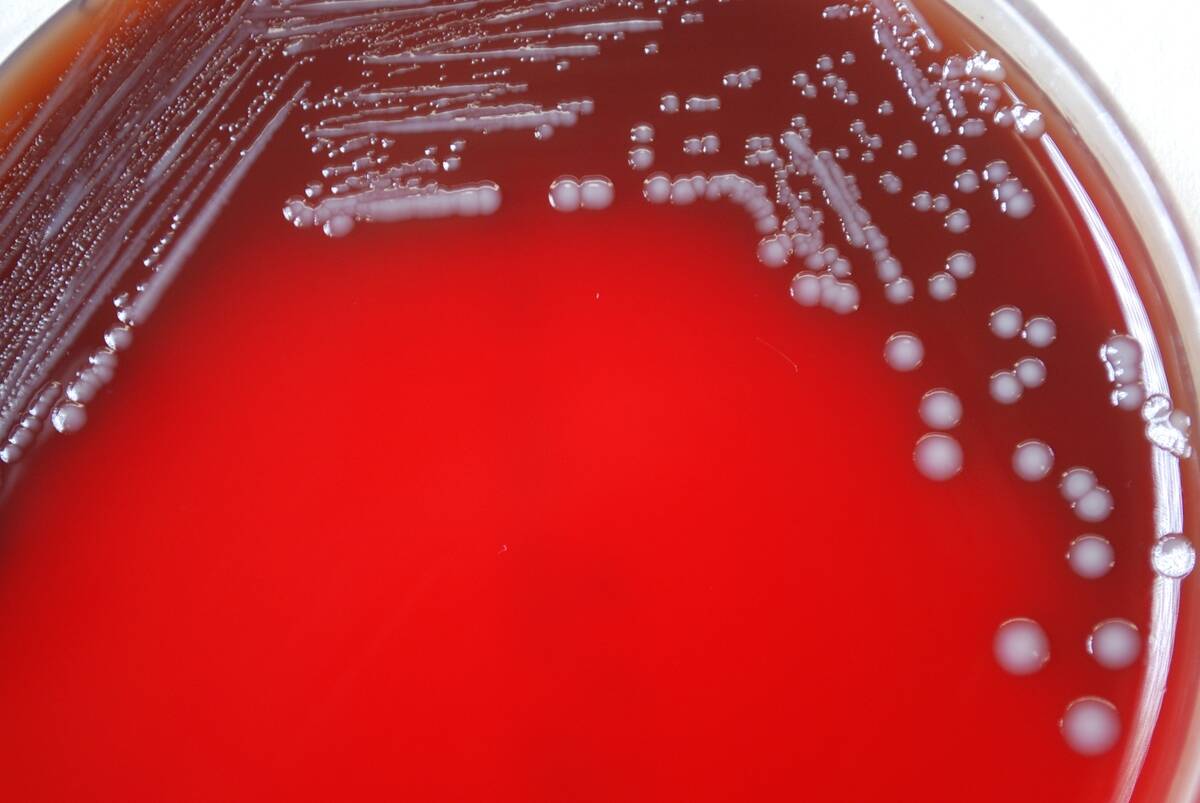
Yersinia Pestis

The unseen microorganisms shaping your indoor spaces
Trending Now
When you think of the architects of your home, you probably envision designers and builders. However, the real architects might be much smaller and more numerous.
Hidden away in nooks and crannies, microorganisms play a crucial role in shaping our indoor environments. These tiny creatures have a surprising impact on everything from air quality to allergies, and even the aesthetics of our living spaces.
Meet the Microscopic Marvels: An Overview of Indoor Microorganisms

Microorganisms are everywhere, and our homes are no exception. They include bacteria, fungi, algae, viruses, and even tiny mites. While some of these may sound concerning, most are harmless and some are even beneficial.
These microorganisms help maintain the balance of our indoor ecosystems, influencing everything from the air we breathe to the way our homes smell.
The Ubiquitous Bacteria: Your Tiny Roommates
Bacteria are some of the most common indoor microorganisms, with millions of them residing in every corner of our homes. They live on surfaces, in the air, and even in our water.
While some bacteria can cause illness, most are innocuous, and some even help break down organic matter and contribute to a healthier living environment.
Fungi Among Us: The Mold and Yeast Connection

Molds and yeasts are types of fungi that can thrive indoors, especially in damp or humid conditions. While molds are often unwelcome due to their potential health impacts, yeasts can be beneficial in processes like fermentation.
Proper ventilation and moisture control can help manage these fungi, ensuring they remain a fascinating, but controlled, part of our indoor ecosystems.
Algae Indoors: More Common Than You Think

Algae isn’t just an outdoor phenomenon; it can appear indoors, particularly in areas with abundant moisture and light. Common places to find algae include bathroom tiles and poorly ventilated basements.
While often harmless, indoor algae can be unsightly. Regular cleaning, moisture control, and adequate lighting can help keep these green invaders at bay.
Viruses: Not Just the Bad Guys

Viruses often get a bad rap, but not all are harmful. Some viruses infect bacteria, helping control bacterial populations, thus maintaining balance in microbial communities.
While it’s important to protect against harmful viruses by practicing good hygiene, it’s fascinating to note that viruses also play roles in the complex web of microbial life in our homes.
Dust Mites and Their Microbial Allies

Dust mites are tiny creatures that thrive in our homes, feeding on dead skin cells. These mites are often accompanied by bacteria and fungi, which together contribute to the breakdown of organic matter.
While they might sound unpleasant, this trio plays a crucial role in recycling nutrients and maintaining the flow of energy in indoor ecosystems.
The Role of Microbes in Air Quality

Microbes in our homes significantly influence air quality. Certain bacteria and fungi can break down volatile organic compounds (VOCs), which are pollutants that can affect health.
Maintaining a balance of these microorganisms can improve air quality, making indoor spaces healthier and more pleasant to inhabit.
How Microorganisms Affect Indoor Allergies

Microorganisms can both trigger and mitigate allergies. Dust mites and mold spores are common allergens, causing sneezing and respiratory issues.
However, exposure to a diverse range of microbes, particularly in childhood, can strengthen the immune system, potentially reducing allergy risks. Striking the right balance is key to managing allergies at home.
Microbial Influence on Home Odors

The smell of our homes can be greatly influenced by microbial activity. Bacteria and fungi produce volatile compounds that contribute to odors. While some smells are unpleasant, others can be quite neutral or even pleasant.
Regular cleaning and ventilation help control these odors, keeping our homes smelling fresh.
The Surprising Benefits of Indoor Microbes
Not all microbes are adversaries; many offer surprising benefits. Certain bacteria can help boost our immune systems, while others aid in digestion and mental health.
The presence of diverse microbial communities can create a more balanced indoor environment, promoting overall well-being for the occupants.
Microorganisms and Your Indoor Plants: A Symbiotic Relationship

Indoor plants and microorganisms share a mutually beneficial relationship. Bacteria in the soil can help plants absorb nutrients more efficiently, while fungi can protect against harmful pathogens.
In return, plants provide these microbes with necessary nutrients, creating a thriving ecosystem that supports both flora and fauna.
How Cleaning Habits Shape Your Microbial Environment

Our cleaning habits have a significant impact on the microbial landscape of our homes. Regular cleaning can control harmful bacteria and fungi, but over-sterilizing may also reduce beneficial microbes.
Finding a balance that keeps harmful microorganisms at bay while allowing beneficial ones to thrive is key to a healthy home environment.
The Impact of Pets on Indoor Microbial Diversity

Pets are more than just furry companions; they also introduce a diverse array of microbes into our homes. These additional microbes can enrich the indoor ecosystem, potentially benefiting human health by boosting the immune system.
Regular grooming and cleaning can manage pet-related microbes, ensuring a harmonious coexistence.
Microbial Life in the Kitchen: Not as Scary as It Sounds

The kitchen is a hotspot for microbial activity, but not all of it is harmful. Many bacteria play roles in food preservation and fermentation, enhancing flavors and extending shelf life.
While it’s important to maintain cleanliness to prevent foodborne illnesses, it’s comforting to know that not all microbial life in the kitchen is a cause for concern.
The Future of Indoor Microbial Research: What’s Next?

As our understanding of indoor microorganisms deepens, future research promises exciting developments. Scientists are exploring how understanding indoor microbial communities could inform building design, ventilation strategies, and cleaning technologies.
Advances in microbiome research could lead to smarter building designs and innovative cleaning solutions, making our homes healthier and more sustainable.




